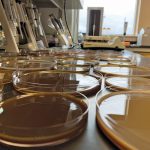

Tag Archives University of Manitoba

Manitoba tick study focuses on testing, other carriers for anaplasmosis
University of Manitoba researchers look into effects of tick and fly diseases in cattle, seek ranchers to participate

Cutting nitrogen in dry beans could pay off for farmers
Manitoba trials test whether farmers can apply less nitrogen to dry beans without losing yield, despite their typically poor nitrogen-fixing capacity

VIDEO: Yield-eating weeds and pest insects tackled at field day
The University of Manitoba put the spotlight on its in-progress crop research, including the concept of a nurse crop against flea beetles, corn weed control and high-protein canola fertilizer

Is canola on the path to withstand verticillium?
Seed companies are starting to tout canola with some verticillium stripe tolerance; meanwhile, researchers have a line on a genetic trait that might physically block infection

University of Manitoba student lays international path
Work involves examination of Prairie berry components to help boost sector

Soil science pioneer honoured with lecture series
The first Ted Poyser Lecture in Soil Health launched at University of Manitoba is imminent

Hormone implants offer clear advantage
In addition to helping the bottom line, hormone implants have a big environmental upside

Giving beef a good rep
FACES OF AG | University of Manitoba research scientist honoured
Creating a canola-based plastic alternative
New research turns canola protein into strong, flexible films meant for food packaging

Happy trails: Award-winning soil scientist retires
Faces of Ag: After 27 years with Manitoba Agriculture, the respected soil fertility specialist has retired